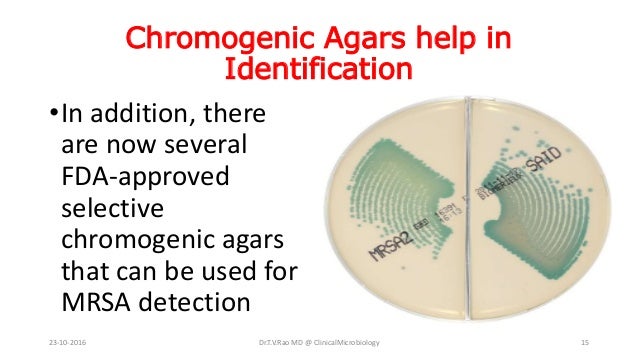
Screening For Mrsa

How To Detect Mrsa. Anti Mrsa Kit - Jetzt Preise vergleichen und sparen. Anzeige Read Janes Story About One Simple Trick To End Severe MRSA Infection. Anzeige Nur heute die Hygienefibel 2021 gratis anfordern. This test involves rubbing a cotton-tipped swab in the patients nostrils or on the skin.
Zu Ihrer eigenen Sicherheit. Test some patients to see if they have MRSA on their skin. Most of the staphylococcus infections usually start with small red bumps that are painful and swollen. Amplification tests like those based on polymerase chain reaction PCR are available to detect the mecA gene. Emuaid Gave Me My Life Back I Am So Thankful For This Amazing Product. Healthcare professional when MRSA skin.
Anzeige Read Janes Story About One Simple Trick To End Severe MRSA Infection.
Emuaid Gave Me My Life Back I Am So Thankful For This Amazing Product. Anzeige Finde aktuelle Preise für Anti Mrsa Kit. Prevent MRSA skin infections. Rapid methods for detection of MRSA in clinical specimens Antimicrobial susceptibility test methods such as disk diffusion broth microdilution and oxacillin screen plate require 24 h of incubation after having the organism growing in pure culture. The cefoxitin disk diffusion method can be used in addition to routine susceptibility test methods or. Latex agglutination methods are available for detection of the penicillin-binding protein 2a PBP2a.